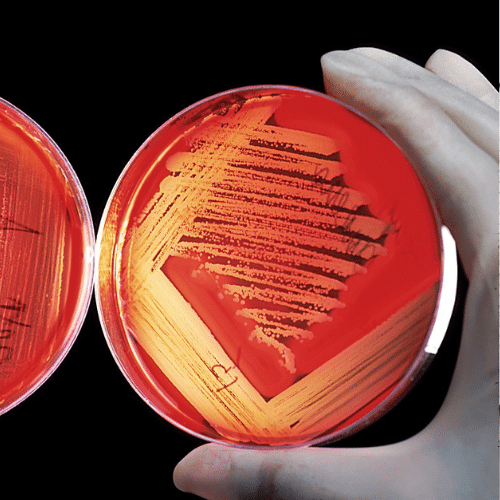

Articles & News
Stay informed with expert insights, industry updates, and practical guidance you can trust. Our articles and news section covers compliance tips, regulatory updates, and best practices to help you make confident decisions and keep your facility aligned with current standards.
- « Previous
- 1
- 2

3115 Mercer Ave Ste 103
Bellingham, WA 98225